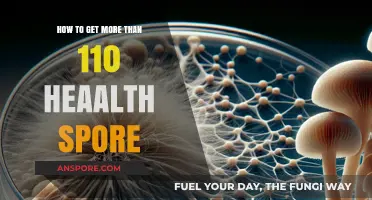
Maximize Your Health Spore Count: Proven Strategies for Over 110

In the Tribe stage of *Spore*, securing more food is crucial for your tribe's survival and growth. To increase your food supply, focus on hunting, foraging, and scavenging efficiently by directing your creatures to gather resources from nearby plants, animals, and carcasses. Upgrading your creature’s abilities, such as speed and strength, will make them more effective at collecting food. Additionally, expanding your tribe’s territory by defeating rival tribes or claiming new areas can unlock access to more abundant food sources. Managing your population and ensuring your creatures are well-fed will also prevent starvation and allow your tribe to thrive as you progress to the next stage of evolution.
| Characteristics | Values |
|---|---|
| Harvesting Plants | Gather food from glowing plants by clicking on them. More plants spawn as you expand your territory. |
| Hunting Creatures | Kill small, slow-moving creatures for food. Use pack tactics or ambushes for easier hunts. |
| Fishing | If near water, use the fishing ability to catch fish for food. |
| Stealing from Nests | Steal food from enemy tribes' nests, but beware of retaliation. |
| Expanding Territory | Claim more territory to access additional food sources and plants. |
| Upgrading Mouth Parts | Evolve sharper teeth or longer tongues to hunt larger prey or reach distant food. |
| Taming Creatures | Tame herbivores to herd them for a steady food supply. |
| Trading with Allies | Form alliances with neighboring tribes to trade for food. |
| Using Spore Flowers | Plant spore flowers to grow additional food sources in your territory. |
| Avoiding Waste | Ensure your tribe members eat efficiently to minimize food loss. |
Explore related products
What You'll Learn
- Hunting Strategies: Learn to track and hunt efficiently to increase meat resources for your tribe
- Farming Techniques: Cultivate berries and spices to ensure a steady, sustainable food supply
- Scavenging Tips: Explore for wild food sources like fruits and carcasses to supplement meals
- Trading Food: Exchange goods with neighboring tribes to acquire additional food resources
- Expanding Territory: Claim new areas with abundant food sources to support tribe growth

Hunting Strategies: Learn to track and hunt efficiently to increase meat resources for your tribe
In the Tribe stage of Spore, meat is a vital resource for sustaining and growing your population. Efficient hunting not only ensures survival but also accelerates your tribe’s development. To maximize meat resources, focus on mastering tracking and hunting techniques that minimize effort while maximizing yield. Start by observing animal behavior patterns—note which creatures are solitary, which travel in herds, and their typical routes. Solitary prey like the Diplodocus is easier to isolate and hunt without attracting unwanted attention, while herding animals like the Gavius offer larger rewards but require strategic planning to avoid scattering the group.
Tracking is an art that hinges on patience and observation. Train your tribe members to follow footprints, scat, and disturbed vegetation, which often indicate recent animal activity. Use the game’s tracking feature to highlight paths and identify high-traffic areas where prey frequently congregates. For example, water sources are natural gathering points for herbivores, making them prime hunting grounds. Position your tribe members strategically around these areas, using the terrain to your advantage. Hills or dense foliage can provide cover, allowing you to ambush prey without alerting others.
Hunting efficiency also depends on understanding your tribe’s capabilities and limitations. Early in the Tribe stage, your creatures are weaker and slower, so prioritize smaller, slower prey like the Gavius or the Diplodocus. As your tribe evolves and gains abilities like pack hunting or increased speed, tackle larger, more dangerous prey like the Epic Cyranor. Always assess the risk-reward ratio—a failed hunt against a powerful creature can result in lost tribe members and wasted resources. Equip your hunters with tools like spears or fire to increase their chances of success, but remember that these tools require resources to craft, so use them judiciously.
A comparative analysis of hunting strategies reveals that group hunting is often more effective than solo efforts, especially for larger prey. Coordinate your tribe members to surround and isolate targets, minimizing the risk of escape. However, this approach requires careful timing and positioning. If one member attacks prematurely, the prey may flee, alerting others and potentially leading predators back to your tribe. Practice patience and synchronization—wait for the optimal moment to strike, ensuring a swift and successful kill.
Finally, consider the long-term sustainability of your hunting practices. Overhunting in a single area can deplete local wildlife, forcing you to travel farther for food. Rotate hunting grounds periodically to allow animal populations to recover. Additionally, balance meat acquisition with other food sources like fruits to reduce reliance on hunting. By integrating these strategies, your tribe can maintain a steady supply of meat while minimizing risks and maximizing efficiency, setting the stage for a thriving civilization in the later stages of Spore.
Determining the Right Number of Spore Syringes for Your Needs
You may want to see also

Farming Techniques: Cultivate berries and spices to ensure a steady, sustainable food supply
In the Tribe stage of Spore, food scarcity can quickly become a bottleneck for your tribe's growth and survival. While hunting and scavenging are immediate solutions, they are unsustainable in the long run. Cultivating berries and spices, however, offers a reliable and renewable food source. By establishing farms, you not only ensure a steady supply but also free up tribe members for other tasks like socializing or defending against predators.
Berry bushes and spice plants are scattered across the map, often near water sources or in lush areas. Identify these locations early and designate tribe members to harvest them regularly. Initially, manual harvesting suffices, but as your tribe grows, consider planting additional crops to meet increasing demand.
The key to successful farming lies in understanding the growth cycles of berries and spices. Berries typically regenerate faster, making them ideal for quick food needs, while spices take longer to mature but provide higher yields. Experiment with different planting patterns and observe which crops thrive in specific environments. For instance, certain spices may grow better in shaded areas, while berries flourish in open, sunny spaces.
To maximize efficiency, assign specific roles within your tribe. Designate gatherers to collect seeds from wild plants, farmers to plant and tend crops, and harvesters to gather the produce. This division of labor ensures that farming operations run smoothly without neglecting other essential tasks. Additionally, protect your farms from predators by stationing guards nearby or building scarecrows to deter unwanted visitors.
While farming requires an initial investment of time and resources, the long-term benefits far outweigh the costs. A well-maintained farm not only sustains your tribe but also allows you to trade surplus food for other resources, fostering alliances with neighboring tribes. By mastering farming techniques, you transform your tribe from a group of scavengers into a thriving, self-sufficient community.
Exploring the Microscopic World: What Do Spores Really Look Like?
You may want to see also

Scavenging Tips: Explore for wild food sources like fruits and carcasses to supplement meals
In the early stages of Spore's Tribe phase, food scarcity can stifle your tribe's growth. Scavenging for wild food sources is a low-risk, high-reward strategy to supplement your meals. Fruits and carcasses are abundant in most environments, requiring only exploration and a keen eye to exploit. Unlike hunting or farming, scavenging demands no tools or skills, making it accessible from the start.
To maximize scavenging efficiency, prioritize areas with dense vegetation or near water sources, as these often harbor fruit-bearing plants. Train your tribe members to recognize ripe fruits by their vibrant colors and avoid toxic varieties, which can be identified by their dull hues or unusual shapes. For carcasses, look for vultures circling overhead or follow the scent of decay, though be cautious of predators still guarding their kill. A well-timed scavenging run can yield enough food to sustain your tribe for several days, freeing up time for other tasks like tool crafting or territory expansion.
While scavenging is reliable, it’s not without risks. Consuming spoiled carcasses can lead to illness, reducing your tribe’s health and productivity. To mitigate this, inspect carcasses for signs of freshness—intact skin and minimal maggot activity are good indicators. Fruits, though generally safer, can still be contaminated by parasites or mold, so always wash them in clean water before consumption. Balancing the risks with the rewards ensures scavenging remains a sustainable food source.
Comparing scavenging to other food-gathering methods highlights its unique advantages. Hunting requires weapons and exposes your tribe to danger, while farming demands time and resources to establish. Scavenging, however, offers immediate results with minimal investment. It’s particularly effective in the early game when your tribe is small and resources are scarce. As your tribe grows, combine scavenging with other strategies to create a diversified food supply, ensuring resilience against environmental changes or resource depletion.
In practice, allocate 2-3 tribe members to scavenging duties daily, rotating roles to prevent fatigue. Equip them with basic tools like sticks for defense and baskets for carrying food. Establish a route that covers both fruit-rich areas and potential carcass sites, optimizing time and effort. Over time, as your tribe develops better tools and knowledge, scavenging can evolve from a survival tactic to a supplementary strategy, freeing up resources for more advanced pursuits like domestication or warfare. Master this skill, and your tribe will thrive even in the harshest environments.
Join Singapore's Military: A Step-by-Step Guide to Enlistment and Service
You may want to see also
Explore related products

Trading Food: Exchange goods with neighboring tribes to acquire additional food resources
In the tribal stage of Spore, food scarcity can quickly become a bottleneck for your tribe's growth and survival. One strategic solution is to leverage trading food by exchanging goods with neighboring tribes. This approach not only secures additional food resources but also fosters alliances and diversifies your tribe's inventory. To initiate trade, identify tribes with surplus food or complementary resources, such as fruits or meat, and offer items they lack, like tools or spices. Successful trades depend on understanding the value each tribe places on different goods, so observe their behavior and inventory before proposing an exchange.
The mechanics of trading in Spore are straightforward but require careful planning. Approach a neighboring tribe and use the trade interface to select items from your inventory to offer. Start with low-value items to gauge their interest, then gradually increase the stakes if they seem receptive. For instance, offering a single tool in exchange for a bundle of fruit can be a fair starting point. Be mindful of tribes that may demand more than they give—always ensure the trade benefits your tribe in the long term. Pro tip: Tribes with different diets or environments often have unique resources, making them ideal trading partners.
A comparative analysis of trading versus foraging reveals its efficiency in resource acquisition. While foraging relies on random discoveries and can be time-consuming, trading provides immediate access to food in predictable quantities. For example, a single successful trade can yield more food than an hour of foraging, especially if the neighboring tribe has a surplus. However, trading is not without risks. Hostile tribes may attack if they perceive your offers as weak or insulting, so always maintain a defensive posture during negotiations. Balancing the benefits of trading with potential risks is key to maximizing its effectiveness.
To optimize your trading strategy, focus on building relationships with multiple tribes. Regularly visit friendly tribes to establish trust and increase the likelihood of favorable trades. Keep a diverse inventory of goods to cater to different tribal needs—for instance, medicinal herbs can be highly valued by tribes with sick members. Additionally, monitor your tribe's food levels and initiate trades before resources run critically low. Practical tip: Use the game's map to track tribes you’ve traded with and their preferred goods, ensuring efficient future exchanges.
In conclusion, trading food is a dynamic and sustainable method to enhance your tribe's food supply in Spore. By understanding tribal values, mastering negotiation tactics, and maintaining strategic relationships, you can secure a steady flow of resources while minimizing risks. This approach not only addresses immediate food needs but also positions your tribe for long-term growth and dominance in the game's ecosystem.
Do Conifers Contain Spores? Exploring Their Reproductive Structures
You may want to see also

Expanding Territory: Claim new areas with abundant food sources to support tribe growth
Expanding your tribe's territory is a strategic move to secure more food and ensure the survival and prosperity of your Spore civilization. This approach requires careful planning and execution, as it involves venturing into uncharted lands and establishing dominance over new resources. Here's a comprehensive guide to this expansion strategy.
Scouting and Exploration: Begin by sending out scouting parties to survey the surrounding areas. Look for regions with diverse ecosystems, as these often indicate a variety of food sources. For instance, areas near water bodies might offer fish, while forests can provide fruits and small game. Identify these hotspots and assess their potential for sustaining your growing tribe. Remember, the key is to find untapped resources that can support your population's dietary needs.
Claiming New Lands: Once you've identified suitable territories, it's time to establish your presence. This process involves more than just physical occupation; it's about creating a sustainable food network. Set up hunting grounds, fishing spots, and gathering sites. Teach your tribe members the skills needed to exploit these resources efficiently. For example, develop fishing techniques for aquatic areas and foraging methods for forest environments. Ensure that these practices are sustainable to maintain the long-term viability of the food sources.
Managing Expansion: Expanding your territory comes with challenges. As you grow, so does the need for organization and resource management. Implement a system to distribute food fairly among tribe members and store surplus for leaner times. Consider the following: create a central storage area, appoint resource managers, and establish trade routes with neighboring tribes to exchange goods. This ensures that your expansion efforts benefit the entire tribe and foster a sense of community.
The Benefits of Diversity: One of the most significant advantages of territorial expansion is the access to a diverse food supply. Different environments offer unique nutritional opportunities. For instance, coastal areas provide seafood rich in omega-3 fatty acids, essential for brain development, while inland forests may yield nutrient-dense berries and nuts. By diversifying your food sources, you improve the overall health and resilience of your tribe, making it better equipped to face various challenges.
In the context of Spore's Tribe stage, expanding territory is a dynamic solution to the constant need for more food. It encourages players to think strategically, considering the environment, resource management, and community building. This approach not only addresses the immediate food requirements but also sets the foundation for a thriving civilization in the later stages of the game. With careful planning and an understanding of the ecosystem, players can create a sustainable and prosperous tribe, ready to evolve and conquer new challenges.
Crafting Spore Blossoms: A Step-by-Step Guide to Magical Creations
You may want to see also
Frequently asked questions
To get more food in the Tribe stage, focus on hunting smaller creatures, gathering fruits from plants, and expanding your tribe to increase the number of members who can forage and hunt.
Efficient food gathering involves scouting the area for fruit-bearing plants, ambushing prey from stealth, and using social interactions to recruit more tribe members who can contribute to food collection.
While you cannot directly trade food, you can attack and defeat other tribes to gain access to their food resources. However, this approach can be risky and may lead to retaliation.